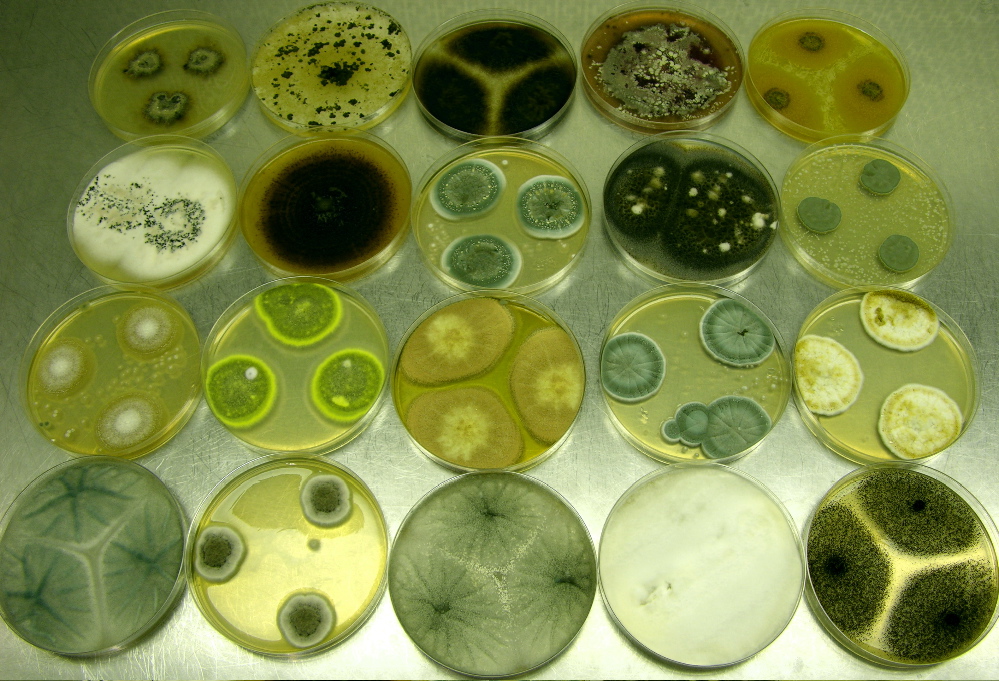
doenças fúngicas

As doenças fúngicas podem ser mais comuns do que você imagina, surgindo de forma discreta e tirando o nosso sossego. Muita gente se incomoda com coceiras, manchas na pele ou unhas que mudam de cor, mas nem sempre associa ao fungo. Pois é, esses micro-organismos estão por toda parte e, em 2026, saber identificá-los e combatê-los é essencial para manter seu bem-estar em dia. Neste artigo, eu vou te mostrar os sinais que você não pode ignorar e os tratamentos que realmente funcionam para você ficar livre dessas infecções. Fica comigo que você vai aprender tudo.
Entendendo as Diferentes Categorias das Doenças Fúngicas e Seus Alvos
As infecções fúngicas se dividem em três grupos principais, dependendo de onde atacam o corpo.
Temos as superficiais e cutâneas, que preferem a camada externa da pele, unhas e cabelos. Elas incluem problemas bem conhecidos como o Pano Branco, o Pé de Atleta e as candidíases.
Depois, vêm as subcutâneas. Essas entram na pele, geralmente por algum corte pequeno. A esporotricose é um exemplo clássico.
Por fim, as sistêmicas são as mais sérias, pois atingem órgãos internos, como os pulmões. Histoplasmose e aspergilose são exemplos que exigem atenção redobrada.
“As doenças fúngicas, também conhecidas como micoses, são infecções causadas por fungos que podem afetar a pele, unhas, cabelos e até órgãos internos. Elas ocorrem quando fungos encontram condições ideais de calor e umidade para se proliferar ou quando o sistema imunológico está fragilizado.”

Doenças Fúngicas em 2026: Um Guia Completo para Entender e Combater Micoses
As doenças fúngicas, também conhecidas como micoses, são infecções causadas por fungos que podem afetar diversas partes do corpo, desde a pele e unhas até órgãos internos. Em 2026, a compreensão dessas condições é fundamental para um diagnóstico precoce e um tratamento eficaz, garantindo sua saúde e bem-estar. É importante desmistificar o assunto e entender que, embora comuns, muitas micoses podem ser prevenidas com medidas simples e tratadas com sucesso.
Neste guia, eu vou detalhar os tipos de infecções fúngicas, seus sintomas mais comuns, as abordagens de tratamento disponíveis e, claro, as melhores estratégias de prevenção. O objetivo é fornecer a você um panorama completo, com a confiança que só a experiência traz, para que você possa cuidar da sua saúde de forma informada e assertiva. Vamos desvendar juntos esse universo e garantir que você esteja preparado.
| Característica | Detalhes |
|---|---|
| Classificação | Superficiais/Cutâneas, Subcutâneas e Sistêmicas |
| Sintomas Comuns | Coceira, vermelhidão, manchas na pele, unhas alteradas. Em casos graves: tosse, cansaço, febre. |
| Tratamento | Antifúngicos (tópicos ou orais) sob prescrição médica. |
| Prevenção | Higiene, secagem adequada, evitar compartilhar objetos pessoais, roupas de algodão. |

Principais Tipos de Micoses
As infecções fúngicas se manifestam de maneiras distintas, dependendo do tipo de fungo e da área do corpo afetada. Essa diversidade exige um olhar atento para cada categoria, pois os mecanismos de infecção e, por vezes, os tratamentos podem variar significativamente. Compreender essa classificação é o primeiro passo para identificar e lidar com a condição de forma adequada.

Micoses Superficiais e Cutâneas
Este é o grupo mais comum de infecções fúngicas. Elas se limitam às camadas mais externas da pele, cabelos e unhas. Exemplos clássicos incluem o temido Pé de Atleta (Tinea pedis), que causa desconforto e coceira entre os dedos dos pés, e a Candidíase, uma infecção oportunista que pode surgir na boca (oral) ou na região genital. Outras micoses frequentes nesta categoria são o Pano Branco (Pitiríase versicolor), caracterizado por manchas na pele, e a Onicomicose, que afeta as unhas, alterando sua cor e textura.

Micoses Subcutâneas
Diferente das superficiais, as micoses subcutâneas penetram um pouco mais profundamente na pele. Geralmente, a infecção ocorre quando há um pequeno corte ou ferimento na pele, servindo como porta de entrada para o fungo. A esporotricose é um exemplo notório, muitas vezes associada ao contato com terra contaminada. Embora menos comuns que as cutâneas, exigem atenção médica para evitar complicações.

Micoses Sistêmicas
Estas são as infecções fúngicas mais graves, pois atingem órgãos internos e podem se espalhar pelo corpo. Fungos presentes no ambiente, como esporos inalados, podem desencadear quadros como a histoplasmose ou a aspergilose, que afetam principalmente os pulmões. Pessoas com o sistema imunológico comprometido são mais vulneráveis a desenvolver essas infecções. Os sintomas podem ser mais gerais, como tosse persistente, fadiga e febre, mimetizando outras doenças.

Sintomas Comuns de Micoses
Ficar atento aos sinais é crucial. A coceira intensa é, sem dúvida, um dos sintomas mais característicos de muitas micoses superficiais. Além disso, você pode notar vermelhidão na área afetada, o surgimento de manchas arredondadas com bordas bem definidas e que podem descamar. No caso das unhas, as alterações na cor (amarelamento, esverdeamento) e na textura (espessamento, quebra fácil) são sinais clássicos de onicomicose. Em infecções sistêmicas, os sintomas se tornam mais difusos, como cansaço inexplicável, tosse crônica e febre baixa persistente.

Tratamento para Doenças Fúngicas
O tratamento para doenças fúngicas é direcionado pelo médico, que avaliará a extensão e o tipo da infecção. Para as micoses superficiais e cutâneas, o uso de antifúngicos em forma de pomadas, cremes, loções ou esmaltes é muito eficaz. Em casos mais resistentes ou quando as unhas são acometidas, o tratamento com antifúngicos orais pode ser necessário. Para as micoses subcutâneas e sistêmicas, o tratamento é mais complexo e geralmente envolve antifúngicos administrados por via oral ou intravenosa, com acompanhamento médico rigoroso. A adesão ao tratamento é vital para a erradicação completa do fungo.
Dicas de Prevenção de Micoses
A prevenção é, sem dúvida, o melhor caminho. Manter a pele e as unhas limpas e secas é o ponto de partida. Preste atenção especial às dobras do corpo, como axilas, virilha e entre os dedos dos pés, secando-as bem após o banho. Evite o uso de roupas muito apertadas e opte por tecidos que permitam a pele respirar, como o algodão. Compartilhar itens pessoais como toalhas, meias e calçados é um convite para a proliferação de fungos, portanto, evite ao máximo. Piscinas e vestiários públicos exigem atenção redobrada; use sempre chinelos.

Quando Procurar um Médico
Embora muitas micoses superficiais possam ser tratadas com produtos de venda livre, é essencial saber quando buscar ajuda profissional. Se os sintomas persistirem por mais de duas semanas, se a infecção se espalhar para outras áreas do corpo, se você notar sinais de inflamação intensa, dor ou se tiver um sistema imunológico enfraquecido, a consulta médica é indispensável. Para micoses subcutâneas ou sistêmicas, a busca por um médico é imediata.

O Veredito Final: Cuidar é Essencial
As doenças fúngicas, em suas diversas manifestações, são condições que exigem atenção, mas que podem ser gerenciadas com sucesso em 2026. A chave está na informação correta, na observação atenta aos sinais do seu corpo e na busca por orientação médica qualificada. Não se trata de um problema intransponível, mas sim de uma questão de saúde que requer cuidado e disciplina.
Investir em prevenção e seguir o tratamento corretamente, conforme as orientações médicas, traz resultados duradouros e evita o agravamento do quadro. Lembre-se, a sua saúde está em suas mãos, e com o conhecimento certo, você está mais preparado do que nunca para enfrentar e vencer as micoses.
Dicas Extras
- Mantenha a pele seca: Após o banho, seque bem todas as áreas do corpo, especialmente as dobras, axilas e virilha. A umidade favorece o crescimento de fungos.
- Use calçados ventilados: Opte por sapatos feitos de materiais que permitam a ventilação, como couro ou tecido. Evite o uso contínuo de calçados sintéticos que retêm umidade.
- Troque de meias diariamente: Se você transpira muito nos pés, troque as meias mais de uma vez ao dia. Meias de algodão são uma boa opção por absorverem a umidade.
- Cuidado com ambientes úmidos: Piscinas, vestiários e academias são locais onde fungos se proliferam. Use chinelos nesses ambientes para evitar o contágio.
- Evite compartilhar objetos pessoais: Toalhas, roupas íntimas, meias e calçados são itens que não devem ser compartilhados para prevenir a disseminação de fungos.
Dúvidas Frequentes
O que são micoses e como se manifestam?
Micoses são infecções causadas por fungos que podem afetar diversas partes do corpo. Os sintomas variam, mas geralmente incluem coceira, vermelhidão, descamação e manchas na pele. É importante observar qualquer alteração e procurar um médico para o diagnóstico correto.
Quais são os tipos de infecções fúngicas mais comuns?
As infecções fúngicas mais comuns são as superficiais e cutâneas, como o Pé de Atleta, a Candidíase e a Pitiríase versicolor (Pano Branco). Existem também as subcutâneas e as sistêmicas, que são mais graves e afetam órgãos internos.
Como posso prevenir o surgimento de fungos na pele e unhas?
A prevenção envolve manter a pele limpa e seca, usar roupas leves e de algodão, evitar andar descalço em locais públicos úmidos e não compartilhar objetos pessoais. Uma boa higiene é fundamental.
Conclusão
As doenças fúngicas, embora comuns, exigem atenção e cuidado. Reconhecer os sinais sutis é o primeiro passo para um tratamento eficaz. Lembre-se que a prevenção é uma aliada poderosa na manutenção da sua saúde. Se você busca aprofundar seus conhecimentos, considere pesquisar mais sobre o Guia Completo: Como Tratar Candidíase em Casa e entender melhor as opções para lidar com essa condição.

